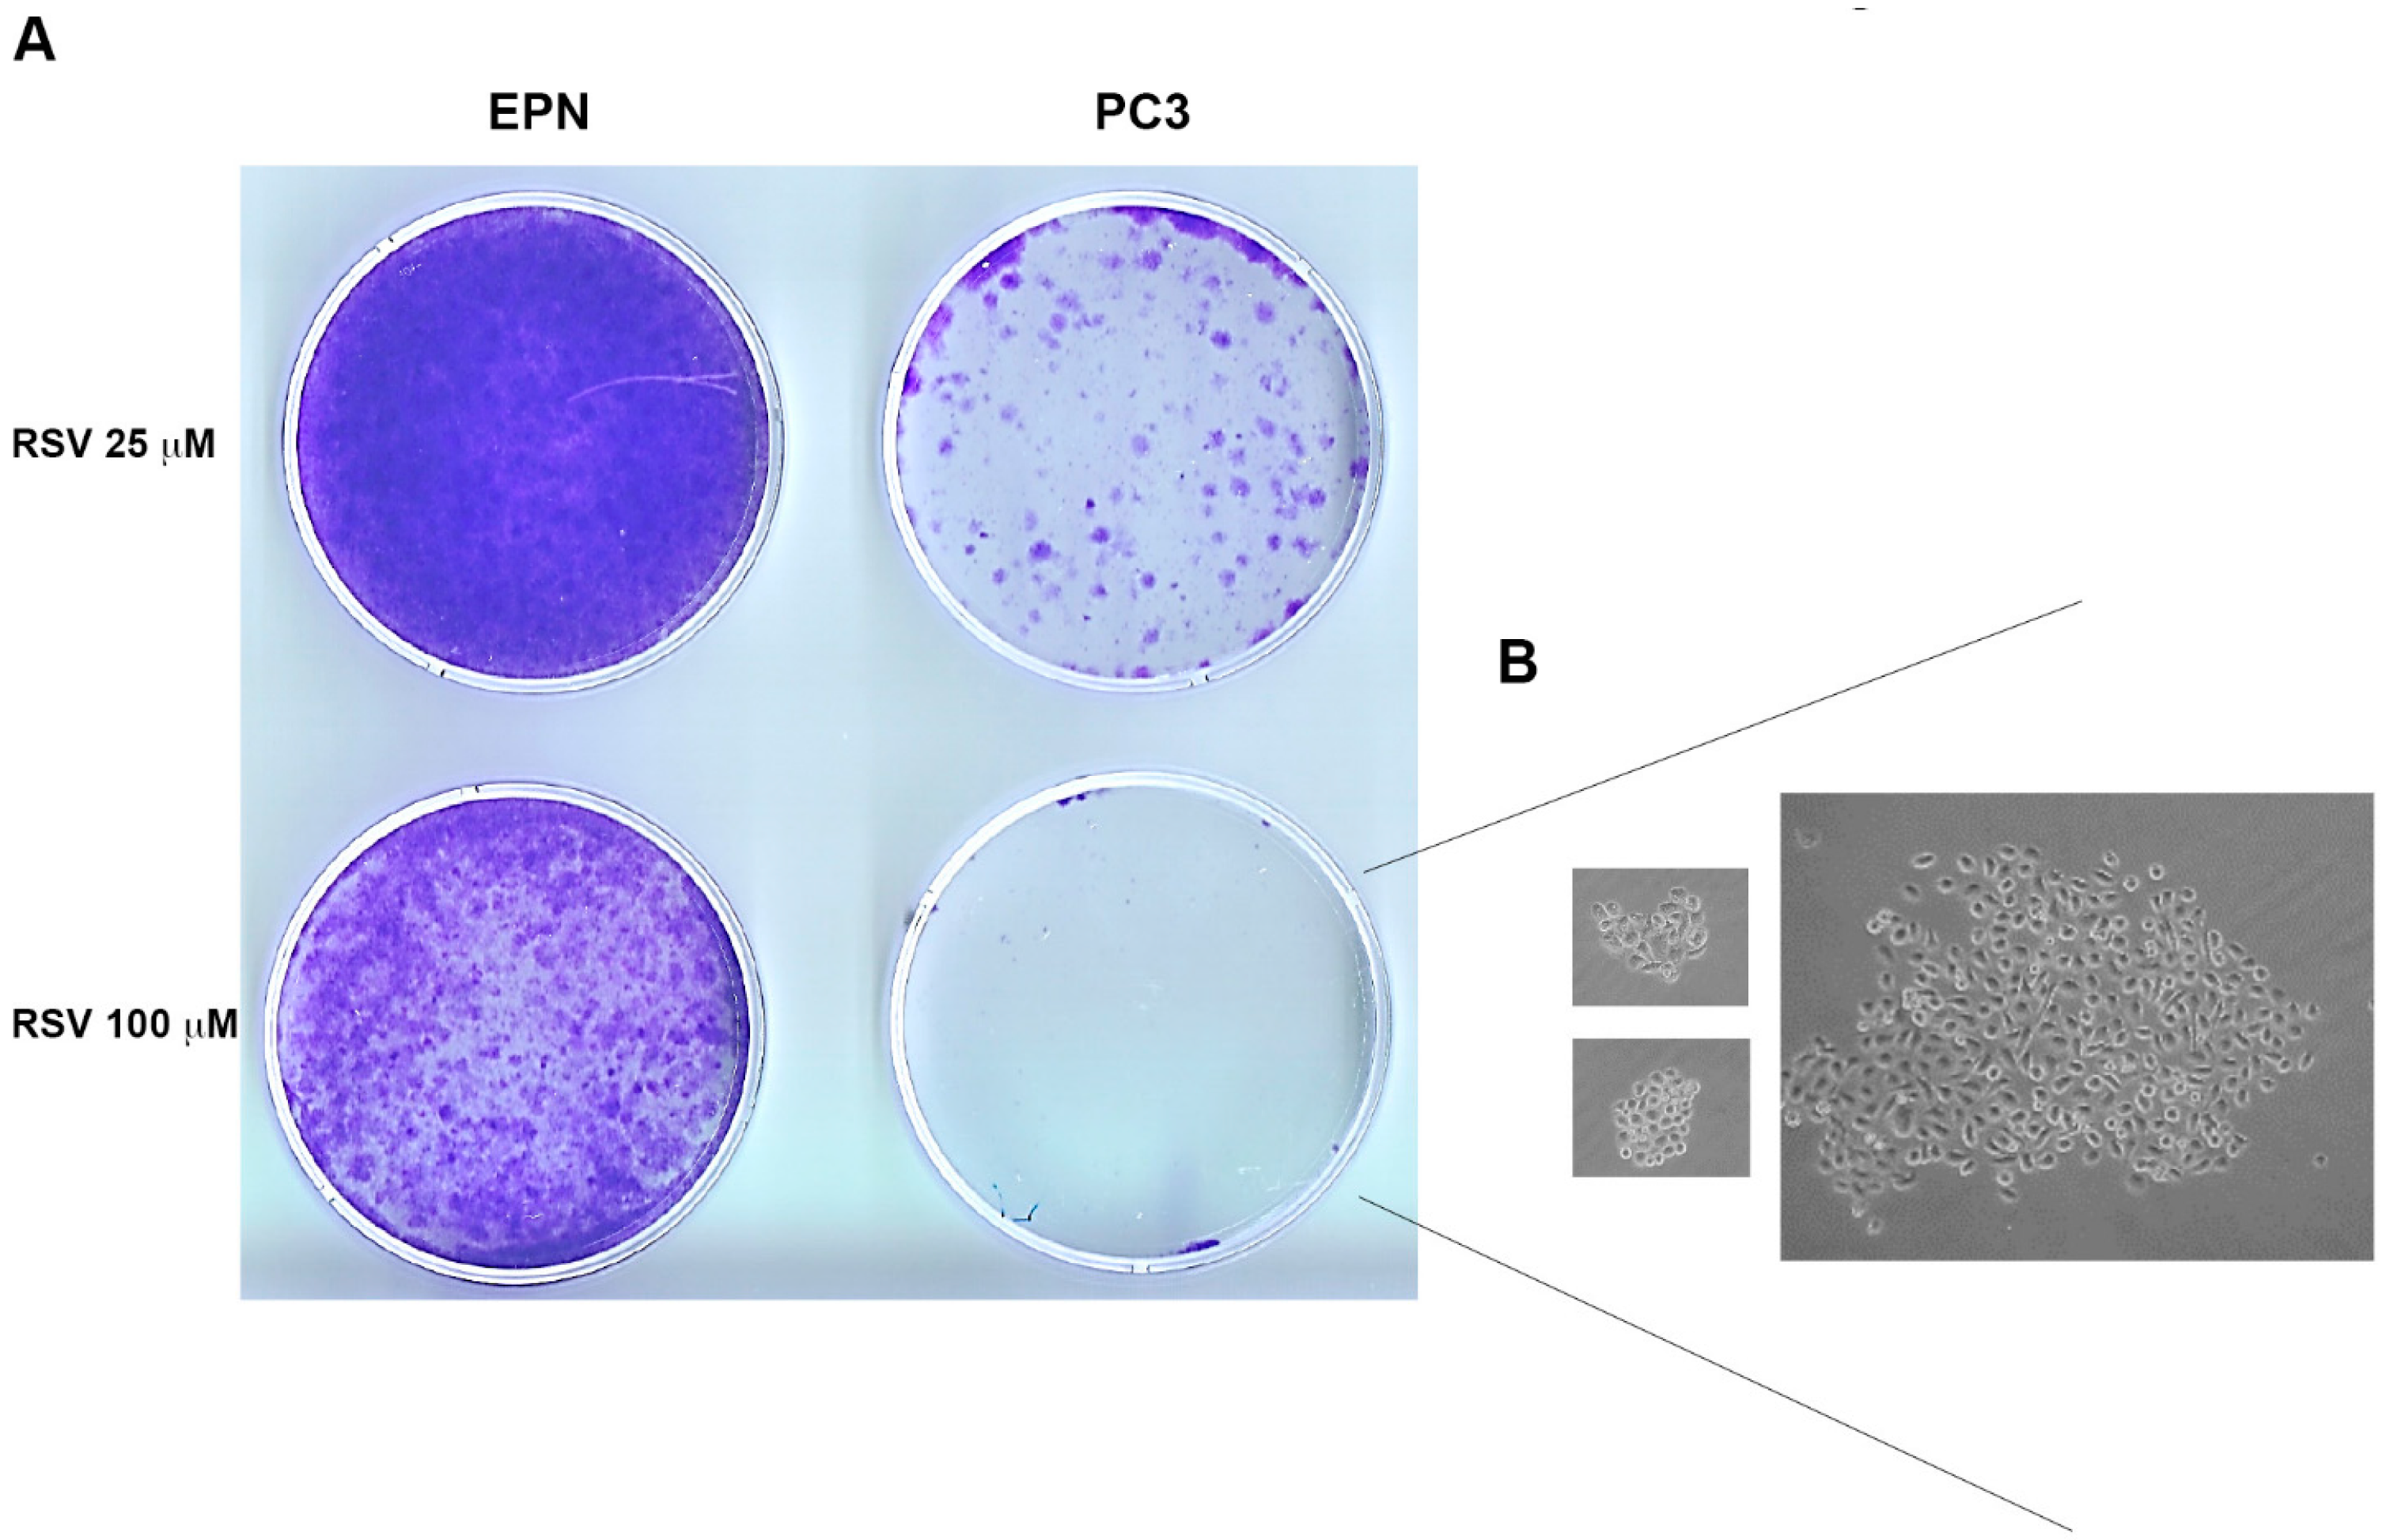

Convergent Effects of Resveratrol and PYK2 on Prostate Cells
Abstract
:1. Introduction
2. Results
2.1. The EPN, EPN-PKM and PC3 Cells Model
2.2. The Effects of PYK2 Mutation and RSV on Basal and H2O2-Induced ROS Production in EPN and EPN-PKM Cells
2.3. RSV Induces Growth Arrest and Morphological Changes in EPN, EPN-PKM and PC3 Cells
2.4. EPN, EPN-PKM and PC3 Cells Proliferation Re-Starts upon Resveratrol Wash-out
2.5. PYK2 Ablation Increases Basal and RSV-Induced Levels of Autophagy in EPN Cells
2.6. PYK2 Knock-down Confirms the Involvement of the Kinase in the Regulation of ROS Production, Autophagy and Sensitivity to RSV in EPN Cells
3. Discussion
4. Experimental Section
4.1. Chemicals
4.2. Antibodies
4.3. Cell Culture and Growth Curve
4.4. Cristal Violet Staining
4.5. Soft Agar Assay
4.6. Measurement of ROS
4.7. Western Blotting
4.8. Flow Cytometry
4.9. Fluorescence Microscopy
4.10. RNA Intereference
4.11. Statistical Analysis
Acknowledgments
Author Contributions
Conflicts of Interest
Appendix A

| One-Way Analysis of Variance | ||||||
|---|---|---|---|---|---|---|
| EPN | EPN-PKM | PC3 | ||||
| Hours of NAC treatment | 48 | 72 | 48 | 72 | 48 | 72 |
| p-Value | <0.0001 | <0.0001 | <0.0001 | <0.0001 | <0.0001 | <0.0001 |
| p-Value summary | *** | *** | *** | *** | *** | *** |
| α p < 0.05 | Yes | Yes | Yes | Yes | Yes | Yes |
| F | 26.06 | 41.51 | 10.82 | 22.09 | 19.3 | 17.41 |
| R square | 0.7363 | 0.8164 | 0.537 | 0.703 | 0.6819 | 0.6511 |
References
- Torre, L.A.; Siegel, R.L.; Ward, E.M.; Jemal, A. Global cancer incidence and mortality rates and trends—An update. Cancer Epidemiol. Biomark. Prev. 2016, 25, 16–27. [Google Scholar] [CrossRef] [PubMed]
- Parikesit, D.; Mochtar, C.A.; Umbas, R.; Hamid, A.R. The impact of obesity towards prostate diseases. Prostate Int. 2016, 4, 1–6. [Google Scholar] [CrossRef] [PubMed]
- Huang, M.; Narita, S.; Numakura, K.; Tsuruta, H.; Saito, M.; Inoue, T.; Horikawa, Y.; Tsuchiya, N.; Habuchi, T. A high-fat diet enhances proliferation of prostate cancer cells and activates MCP-1/CCR2 signaling. Prostate 2012, 72, 1779–1788. [Google Scholar] [CrossRef] [PubMed]
- Shankar, E.; Bhaskaran, N.; MacLennan, G.T.; Liu, G.; Daneshgari, F.; Gupta, S. Inflammatory signaling involved in high-fat diet induced prostate diseases. J. Urol. Res. 2015, 2, 1018. [Google Scholar] [PubMed]
- Paschos, A.; Pandya, R.; Duivenvoorden, W.C.; Pinthus, J.H. Oxidative stress in prostate cancer: Changing research concepts towards a novel paradigm for prevention and therapeutics. Prostate Cancer Prostatic Dis. 2013, 16, 217–225. [Google Scholar] [CrossRef] [PubMed]
- Panieri, E.; Santoro, M.M. ROS homeostasis and metabolism: A dangerous liason in cancer cells. Cell Death Dis. 2016, 7, e2253. [Google Scholar] [CrossRef] [PubMed]
- Lim, S.D.; Sun, C.; Lambeth, J.D.; Marshall, F.; Amin, M.; Chung, L.; Petros, J.A.; Arnold, R.S. Increased Nox1 and hydrogen peroxide in prostate cancer. Prostate 2005, 62, 200–207. [Google Scholar] [CrossRef] [PubMed]
- Pervaiz, S.; Holme, A.L. RSV: Its biologic targets and functional activity. Antioxid. Redox Signal. 2009, 11, 2851–2897. [Google Scholar] [CrossRef] [PubMed]
- Chung, J.H.; Manganiello, V.; Dyck, J.R. RSV as a calorie restriction mimetic: Therapeutic implications. Trends Cell Biol. 2012, 22, 546–554. [Google Scholar] [CrossRef] [PubMed]
- Raj, P.; Lieben Louis, X.; Thandapilly, S.J.; Movahed, A.; Zieroth, S.; Netticadan, T. Potential of RSV in the treatment of heart failure. Life Sci. 2014, 95, 63–71. [Google Scholar] [CrossRef] [PubMed]
- Kma, L. Synergistic effect of RSV and radiotherapy in control of cancers. Asian Pac. J. Cancer Prev. 2013, 14, 6197–6208. [Google Scholar] [CrossRef] [PubMed]
- Sheth, S.; Jajoo, S.; Kaur, T.; Mukherjea, D.; Sheehan, K.; Rybak, L.P.; Ramkumar, V. Resveratrol reduces prostate cancer growth and metastasis by inhibiting the Akt/microRNA-21 pathway. PLoS ONE 2012, 7, e51655. [Google Scholar] [CrossRef] [PubMed]
- Carter, L.G.; D’Orazio, J.A.; Pearson, K.J. RSV and cancer: A focus on in vivo evidence. Endocr. Relat. Cancer 2014, 21, 209–225. [Google Scholar] [CrossRef] [PubMed]
- Hsieh, T.; Lu, X.; Guo, J.; Wu, J.M. Differential regulation of proliferation; cell cycle control and gene expression in cultured human aortic and pulmonary artery endothelial cells by RSV. Int. J. Mol. Med. 2010, 26, 743–749. [Google Scholar] [PubMed]
- Kaisar, M.A.; Cucullo, L. OTC Antioxidant Products for the Treatment of Cardiovascular and other Disorders: Popular Myth or Fact? J. Pharmacovigil. 2015. [Google Scholar] [CrossRef] [PubMed]
- Georgieva, M.; Valkova, I.; Zlatkov, B.; Andonova, L.; Zlatkov, A. RSV: Recommending its wide increase—A premature decision or not? A Review. Int. J. Pharm. Sci. Res. 2015, 6, 3641–3653. [Google Scholar]
- Chen, F.P.; Chien, M.H. Phytoestrogens induce differential effects on both normal and malignant human breast cells in vitro. Climacteric 2014, 17, 682–691. [Google Scholar] [CrossRef] [PubMed]
- Posadino, A.M.; Cossu, A.; Giordo, R.; Zinellu, A.; Sotgia, S.; Vardeu, A.; Hoa, P.T.; Nguyen le, H.V.; Carru, C.; Pintus, G. RSV alters human endothelial cells redox state and causes mitochondrial-dependent cell death. Food Chem. Toxicol. 2015, 78, 10–16. [Google Scholar] [CrossRef] [PubMed]
- Garcia, P.; Schmiedlin-Ren, P.; Mathias, J.S.; Tang, H.; Christman, G.M.; Zimmermann, E.M. RSV causes cell cycle arrest, decreased collagen synthesis, and apoptosis in rat intestinal smooth muscle cells. Am. J. Physiol. Gastrointest. Liver Physiol. 2012, 302, G326–G335. [Google Scholar] [CrossRef] [PubMed]
- Pastore, S.; Lulli, D.; Maurelli, R.; Dellambra, E.; De Luca, C.; Korkina, L.G. Resveratrol induces long-lasting IL-8 expression and peculiar EGFR activation/distribution in human keratinocytes: Mechanisms and implications for skin administration. PLoS ONE 2013, 8, e59632. [Google Scholar] [CrossRef] [PubMed]
- King, R.E.; Kent, K.D.; Bomser, J.A. RSV reduces oxidation and proliferation of human retinal pigment epithelial cells via extracellular signal-regulated kinase inhibition. Chem. Biol. Interact. 2005, 151, 143–149. [Google Scholar] [CrossRef] [PubMed]
- Szende, B.; Tyihak, E.; Kiraly-Veghely, Z. Dose-dependent effect of RSV on proliferation and apoptosis in endothelial and tumor cell cultures. Exp. Mol. Med. 2000, 32, 88–92. [Google Scholar] [CrossRef] [PubMed]
- Fabbrocini, G.; Kisslinger, A.; Iannelli, P.; Vitale, N.; Procaccini, C.; Sparaneo, G.; Chieffi, P.; Ayala, F.; Mancini, F.P.; Tramontano, D. Resveratrol regulates p66Shc activation in HaCaT cells. Exp. Dermatol. 2010, 19, 895–903. [Google Scholar] [CrossRef] [PubMed]
- Vitale, N.; Kisslinger, A.; Paladino, S.; Procaccini, C.; Matarese, G.; Pierantoni, G.M.; Mancini, F.P.; Tramontano, D. RSV couples apoptosis with autophagy in UVB-irradiated HaCaT cells. PLoS ONE 2013, 8, e80728. [Google Scholar] [CrossRef] [PubMed]
- Sinisi, A.A.; Chieffi, P.; Pasquali, D.; Kisslinger, A.; Staibano, S.; Bellastella, A.; Tramontano, D. EPN: A novel epithelial cell line derived from human prostate tissue. In Vitro Cell Dev. Biol. Anim. 2002, 38, 165–172. [Google Scholar] [CrossRef]
- Conte, A.; Procaccini, C.; Iannelli, P.; Kisslinger, A.; De Amicis, F.; Pierantoni, G.M.; Mancini, F.P.; Matarese, G.; Tramontano, D. Effects of Resveratrol on p66Shc phosphorylation in cultured prostate cells. Transl. Med. UniSa 2016, 13, 47–58. [Google Scholar] [PubMed]
- Tokiwa, G.; Dikic, I.; Lev, S.; Schlessinger, J. Activation of Pyk2 by stress signals and coupling with JNK signaling pathway. Science 1996, 273, 792–794. [Google Scholar] [CrossRef] [PubMed]
- Dikic, I.; Tokiwa, G.; Lev, S.; Courtneidge, S.A.; Schlessinger, J. A role for Pyk2 and Src in linking G-protein-coupled receptors with MAP kinase activation. Nature 1996, 383, 547–550. [Google Scholar] [CrossRef] [PubMed]
- Ivankovic-Dikic, I.; Grönroos, E.; Blaukat, A.; Barth, B.U.; Dikic, I. Pyk2 and FAK regulate neurite outgrowth induced by growth factors and integrins. Nat. Cell Biol. 2000, 29, 574–581. [Google Scholar] [CrossRef] [PubMed]
- Stanzione, R.; Picascia, A.; Chieffi, P.; Imbimbo, C.; Palmieri, A.; Mirone, V.; Staibano, S.; Franco, R.; de Rosa, G.; Schlessinger, J.; et al. Variations of proline-rich kinase Pyk2 expression correlate with prostate cancer progression. Lab. Investig. 2001, 81, 51–59. [Google Scholar] [CrossRef] [PubMed]
- Picascia, A.; Stanzione, R.; Chieffi, P.; Kisslinger, A.; Dikic, I.; Tramontano, D. Proline-rich tyrosine kinase 2 regulates proliferation and differentiation of prostate cells. Mol. Cell. Endocrinol. 2002, 186, 81–87. [Google Scholar] [CrossRef]
- De Amicis, F.; Lanzino, M.; Kisslinger, A.; Calì, G.; Chieffi, P.; Andò, S.; Mancini, F.P.; Tramontano, D. Loss of proline rich tyrosine kinase 2 function induces spreading and motility of epithelial prostate cells. J. Cell. Physiol. 2006, 209, 74–80. [Google Scholar] [CrossRef] [PubMed]
- Lin, H.Y.; Lansing, L.; Merillon, J.M.; Davis, F.B.; Tang, H.Y.; Shih, A.; Vitrac, X.; Krisa, S.; Keating, T.; Cao, H.J.; et al. Integrin αVβ3 contains a receptor site for resveratrol. FASEB J. 2006, 20, 1742–1744. [Google Scholar] [CrossRef] [PubMed]
- McCalley, A.E.; Kaja, S.; Payne, A.J.; Koulen, P. Resveratrol and calcium signaling: Molecular mechanisms and clinical relevance. Molecules 2014, 19, 7327–7340. [Google Scholar] [CrossRef] [PubMed]
- Martel-Gallegos, G.; Casas-Pruneda, G.; Ortega-Ortega, F.; Sánchez-Armass, S.; Olivares-Reyes, J.A.; Diebold, B.; Pérez-Cornejo, P.; Arreola, J. Oxidative stress induced by P2X7 receptor stimulation in murine macrophages is mediated by c-Src/Pyk2 and ERK1/2. Biochim. Biophys. Acta 2013, 1830, 4650–4659. [Google Scholar] [CrossRef] [PubMed]
- Davies, P.F.; Civelek, M.; Fang, Y.; Fleming, I. The atherosusceptible endothelium: Endothelial phenotypes in complex haemodynamic shear stress regions in vivo. Cardiovasc. Res. 2013, 99, 315–327. [Google Scholar] [CrossRef] [PubMed]
- Gao, C.; Blystone, S.D. A Pyk2-Vav1 complex is recruited to β3-adhesion sites to initiate Rho activation. Biochem. J. 2009, 420, 49–56. [Google Scholar] [CrossRef] [PubMed]
- Leonard, S.S.; Xia, C.; Jiang, B.H.; Stinefelt, B.; Klandorf, H.; Harris, G.K.; Shi, X. Resveratrol scavenges reactive oxygen species and effects radical-induced cellular responses. Biochem. Biophys. Res. Commun. 2003, 309, 1017–1026. [Google Scholar] [CrossRef] [PubMed]
- Rubiolo, J.A.; Mithieux, G.; Vega, F.V. Resveratrol protects primary rat hepatocytes against oxidative stress damage: Activation of the Nrf2 transcription factor and augmented activities of antioxidant enzymes. Eur. J. Pharmacol. 2008, 591, 66–72. [Google Scholar] [CrossRef] [PubMed]
- Ahmad, K.A.; Clement, M.V.; Pervaiz, S. Pro-oxidant activity of low doses of resveratrol inhibits hydrogen peroxide-induced apoptosis. Ann. N. Y. Acad. Sci. 2003, 1010, 365–373. [Google Scholar] [CrossRef] [PubMed]
- Martins, L.A.; Coelho, B.P.; Behr, G.; Pettenuzzo, L.F.; Souza, I.C.; Moreira, J.C.; Borojevic, R.; Gottfried, C.; Guma, F.C. Resveratrol induces pro-oxidant effects and time-dependent resistance to cytotoxicity in activated hepatic stellate cells. Cell Biochem. Biophys. 2014, 68, 247–257. [Google Scholar] [CrossRef] [PubMed]
- Hart, P.C.; Mao, M.; de Abreu, A.L.; Ansenberger-Fricano, K.; Ekoue, D.N.; Ganini, D.; Kajdacsy-Balla, A.; Diamond, A.M.; Minshall, R.D.; Consolaro, M.E.; et al. MnSOD upregulation sustains the Warburg effect via mitochondrial ROS and AMPK-dependent signalling in cancer. Nat. Commun. 2015, 6, 6053. [Google Scholar] [CrossRef] [PubMed]
- Cagnol, S.; Chambard, J.C. ERK and cell death: Mechanisms of ERK-induced cell death—Apoptosis; autophagy and senescence. FEBS J. 2010, 277, 2–21. [Google Scholar] [CrossRef] [PubMed]
- Park, J.I. Growth arrest signaling of the Raf/MEK/ERK pathway in cancer. Front. Biol. 2014, 9, 95–103. [Google Scholar] [CrossRef] [PubMed]
- Pestell, R.G. New roles of cyclin D1. Am. J. Pathol. 2013, 183, 3–9. [Google Scholar] [CrossRef] [PubMed]
- Amini, A.; Masoumi-Moghaddam, S.; Ehteda, A.; Lawson Morris, D. Bromelain and N-acetylcysteine inhibit proliferation and survival of gastrointestinal cancer cells in vitro: Significance of combination therapy. J. Exp. Clin. Cancer Res. 2014, 33, 92. [Google Scholar] [CrossRef] [PubMed]
- Supabphol, A.; Supabphol, R. Antimetastatic potential of N-acetylcysteine on human prostate cancer cells. J. Med. Assoc. Thail. 2012, 95, S56–S62. [Google Scholar]
- Vang, O. Resveratrol: Challenges in analyzing its biological effects. Ann. N. Y. Acad. Sci. 2015, 1348, 161–170. [Google Scholar] [CrossRef] [PubMed]
- Park, D.; Jeong, H.; Lee, M.N.; Koh, A.; Kwon, O.; Yang, Y.R.; Noh, J.; Suh, P.G.; Park, H.; Ryu, S.H. Resveratrol induces autophagy by directly inhibiting mTOR through ATP competition. Sci. Rep. 2016, 6, 21772. [Google Scholar] [CrossRef] [PubMed]
- Periyasamy, P.; Guo, M.L.; Buch, S. Cocaine induces astrocytosis through ER stress-mediated activation of autophagy. Autophagy 2016, 23, 1–20. [Google Scholar] [CrossRef] [PubMed]
- Mizushima, N.; Yoshimori, T. How to interpret LC3 immunoblotting. Autophagy 2007, 3, 542–545. [Google Scholar] [CrossRef] [PubMed]
- Munafo, D.B.; Colombo, M.I. A novel assay to study autophagy: Regulation of autophagosome vacuole size by amino acid deprivation. J. Cell Sci. 2001, 114, 3619–329. [Google Scholar] [PubMed]
- Erdogan, C.S.; Vang, O. Challenges in Analyzing the Biological Effects of Resveratrol. Nutrients 2016, 8, 6. [Google Scholar] [CrossRef] [PubMed]
- Filomeni, G.; de Zio, D.; Cecconi, F. Oxidative stress and autophagy: The clash between damage and metabolic needs. Cell Death Differ. 2015, 22, 377–388. [Google Scholar] [CrossRef] [PubMed]
- Tanida, I. Autophagosome formation and molecular mechanism of autophagy. Antioxid. Redox Signal. 2011, 14, 2201–2214. [Google Scholar] [CrossRef] [PubMed]
- Wild, P.; McEwan, D.G.; Dikic, I. The LC3 interactome at a glance. J. Cell Sci. 2014, 127, 3–9. [Google Scholar] [CrossRef] [PubMed]
- Ueda, H.; Abbi, S.; Zheng, C.; Guan, J.L. Suppression of Pyk2 kinase and cellular activities by FIP200. J. Cell Biol. 2000, 149, 423–430. [Google Scholar] [CrossRef] [PubMed]
- Bae, H.; Guan, J.L. Suppression of autophagy by FIP200 deletion impairs DNA damage repair and increases cell death upon treatments with anticancer agents. Mol. Cancer Res. 2011, 9, 1232–1241. [Google Scholar] [CrossRef] [PubMed]
- Delmas, D.; Solary, E.; Latruffe, N. RSV, a phytochemical inducer of multiple cell death pathways: Apoptosis; autophagy and mitotic catastrophe. Curr. Med. Chem. 2011, 18, 1100–1121. [Google Scholar] [CrossRef] [PubMed]
- Cai, H.; Scott, E.; Kholghi, A.; Andreadi, C.; Rufini, A.; Karmokar, A.; Britton, R.G.; Horner-Glister, E.; Greaves, P.; Jawad, D.; et al. Cancer chemoprevention: Evidence of a nonlinear dose response for the protective effects of resveratrol in humans and mice. Sci. Transl. Med. 2015. [Google Scholar] [CrossRef] [PubMed]
- Fang, P.; Durhuus, A.J. Resveratrol- and Rapamycin-induced Morphological Changes to Human Epithelial Colon Cancer DLD-1 Cells. Molecular Biology. Ph.D. Thesis, Roskilde University, Roskilde, Denmark, 2008. [Google Scholar]
- Baribeau, S.; Chaudhry, P.; Parent, S.; Asselin, É. Resveratrol inhibits cisplatin-induced epithelial-to-mesenchymal transition in ovarian cancer cell lines. PLoS ONE 2014, 9, e86987. [Google Scholar] [CrossRef] [PubMed]
- Fingar, D.C.; Salama, S.; Tsou, C.; Harlow, E.; Blenis, J. Mammalian cell size is controlled by mTOR and its downstream targets S6K1 and 4EBP1/eIF4E. Genes Dev. 2002, 16, 1472–1487. [Google Scholar] [CrossRef] [PubMed]
- Le Gal, K.; Ibrahim, M.X.; Wiel, C.; Sayin, V.I.; Akula, M.K.; Karlsson, C.; Dalin, M.G.; Akyürek, L.M.; Lindahl, P.; Nilsson, J.; et al. Antioxidants can increase melanoma metastasis in mice. Sci. Transl. Med. 2015. [Google Scholar] [CrossRef] [PubMed]
- Piskounova, E.; Agathocleous, M.; Murphy, M.M.; Hu, Z.; Huddlestun, S.E.; Zhao, Z.; Leitch, A.M.; Johnson, T.M.; DeBerardinis, R.J.; Morrison, S.J. Oxidative stress inhibits distant metastasis by human melanoma cells. Nature 2015, 527, 186–191. [Google Scholar] [CrossRef] [PubMed]
- Pierantoni, G.M.; Conte, A.; Rinaldo, C.; Tornincasa, M.; Gerlini, R.; Valente, D.; Izzo, A.; Fusco, A. Hmga1 null mouse embryonic fibroblasts display downregulation of spindle assembly checkpoint gene expression associated to nuclear and karyotypic abnormalities. Cell Cycle 2016, 15, 812–818. [Google Scholar] [CrossRef] [PubMed]
- Pierantoni, G.M.; Conte, A.; Rinaldo, C.; Tornincasa, M.; Gerlini, R.; Federico, A.; Valente, D.; Medico, E.; Fusco, A. Deregulation of HMGA1 expression induces chromosome instability through regulation of spindle assembly checkpoint genes. Oncotarget 2015, 6, 17342–17353. [Google Scholar] [CrossRef] [PubMed]

© 2016 by the authors; licensee MDPI, Basel, Switzerland. This article is an open access article distributed under the terms and conditions of the Creative Commons Attribution (CC-BY) license (http://creativecommons.org/licenses/by/4.0/).
Share and Cite
Conte, A.; Kisslinger, A.; Procaccini, C.; Paladino, S.; Oliviero, O.; De Amicis, F.; Faicchia, D.; Fasano, D.; Caputo, M.; Matarese, G.; et al. Convergent Effects of Resveratrol and PYK2 on Prostate Cells. Int. J. Mol. Sci. 2016, 17, 1542. https://doi.org/10.3390/ijms17091542
Conte A, Kisslinger A, Procaccini C, Paladino S, Oliviero O, De Amicis F, Faicchia D, Fasano D, Caputo M, Matarese G, et al. Convergent Effects of Resveratrol and PYK2 on Prostate Cells. International Journal of Molecular Sciences. 2016; 17(9):1542. https://doi.org/10.3390/ijms17091542
Chicago/Turabian StyleConte, Andrea, Annamaria Kisslinger, Claudio Procaccini, Simona Paladino, Olimpia Oliviero, Francesca De Amicis, Deriggio Faicchia, Dominga Fasano, Marilena Caputo, Giuseppe Matarese, and et al. 2016. "Convergent Effects of Resveratrol and PYK2 on Prostate Cells" International Journal of Molecular Sciences 17, no. 9: 1542. https://doi.org/10.3390/ijms17091542
APA StyleConte, A., Kisslinger, A., Procaccini, C., Paladino, S., Oliviero, O., De Amicis, F., Faicchia, D., Fasano, D., Caputo, M., Matarese, G., Pierantoni, G. M., & Tramontano, D. (2016). Convergent Effects of Resveratrol and PYK2 on Prostate Cells. International Journal of Molecular Sciences, 17(9), 1542. https://doi.org/10.3390/ijms17091542

